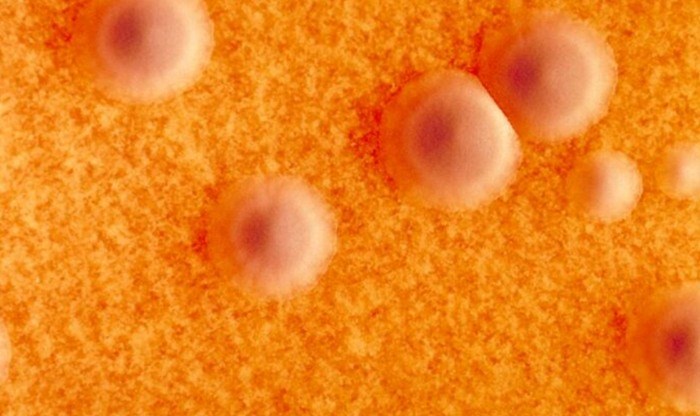
ພະຍາດຄໍຕີບ ເຮັດໃຫ້ປະຊາຊົນໃນກີນີ ເສຍຊີວິດ ຫຼາຍກວ່າ 50 ຄົນ

ຂ່າວຕ່າງປະເທດລາຍງານ ເມື່ອທ້າຍອາທິດຜ່ານມາ, ອົງການອະນາໄມໂລກ (WHO) ໄດ້ອອກຖະແຫຼງການໂດຍລະບຸວ່າ: ກີນີ ຊຶ່ງເປັນປະເທດທີ່ຕັ້ງຢູ່ທາງພາກຕາເວັນຕົກຂອງທະວີບອາຟຣິກາ ຢືນຢັນຜູ້ເສຍຊີວິດຈາກພະຍາດຄໍຕີບແລ້ວ 58 ຄົນ ນັບຕັ້ງແຕ່ເດືອນກໍລະກົດຜ່ານມາ ແລະ ມີຜູ້ປ່ວຍຫຼາຍກວ່າ 500 ຄົນ ສ່ວນຫຼາຍຢູ່ພາກຕາເວັນອອກສ່ຽງເໜືອຂອງປະເທດ.
ທັງນີ້, ລັດຖະບານກີນີຍອມຮັບວ່າ: ບໍ່ມີສັກກະຍະພາບດ້ານສາທາລະນະສຸກພຽງພໍຕໍ່ການປ້ອງກັນປະຊາຊົນຈາກພະຍາດຄໍຕີບ ໂດຍສະເພາະເດັກນ້ອຍ ຊຶ່ງເປັນກຸ່ມສ່ຽງຈາກການທີ່ອັດຕາການໄດ້ຮັບວັກຊີນປ້ອງກັນພະຍາດດັ່ງກ່າວຂອງປະຊາຊົນພາຍໃນປະເທດຕ່ຳກວ່າ 50% ເມື່ອປີ 2014 ແຕ່ເກນຂອງ WHO ກຳນົດໄວ້ລະຫວ່າງ 80%-85% ເພື່ອໃຫ້ພຽງພໍສ້າງພູມຄຸ້ມກັນໝູ່. ອີກຢ່າງໜຶ່ງ, ພະຍາດຄໍຕີບເປັນພາວະຕິດເຊື້ອຮຸນແຮງທີ່ລະບົບທາງເດີນຫາຍໃຈ ເປັນຜົນມາຈາກການຕິດເຊື້ອແບັກທີເຣຍໃນຄົນເຈັບໜັກ ອາດຈະເກີດຈາກພາວະແຊກຊ້ອນແຜ່ລາມໄປຈົນເຖິງການເຮັດວຽກຂອງລະບົບປະສາດ ແລະ ຫົວໃຈ ສົ່ງຜົນໃຫ້ເຖິງແກ່ການເສຍຊີວິດ ເຖິງແມ່ນວ່າອັດຕາການເສຍຊີວິດຈະຢູ່ລະຫວ່າງ 5%-10% ແຕ່ຈະສູງກວ່ານັ້ນຫຼາຍຖ້າຫາກທຽບໃສ່ສະເພາະເດັກນ້ອຍ ຊຶ່ງເປັນກຸ່ມສ່ຽງສູງທີ່ສຸດ.

ຄໍາເຫັນ